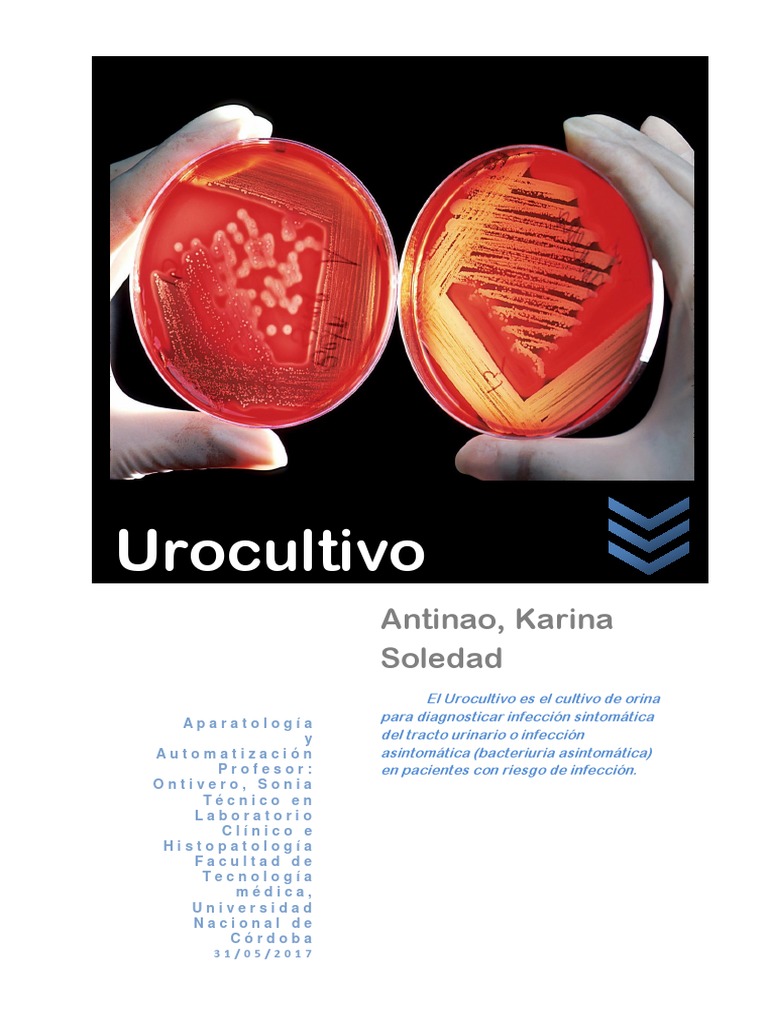
Urocultivo Orina Microbiología

Evolución Del Universo Origen, Teorías, Línea De Tiempo Y Más

El Cosmos y el Universo. Cosmos: Es un sistema ordenado o armonioso. Se origina del termino griego "κόσμος", que significa orden u ornamentos, y es la antítesis del caos. Hoy la palabra se suele utilizar como sinónimo de universo (considerando el orden que éste posee). Universo: El universo es la totalidad del espacio y del tiempo, de.
Composición De La Estructura Del Universo Y Del Cosmos Etiquetada Ilustración Vectorial

El universo es el todo que nos rodea, mientras que el cosmos es una visión más amplia y filosófica del universo, que busca encontrar un sentido y una conexión entre todas las cosas. El cosmos y el universo son dos conceptos relacionados pero diferentes. El cosmos es una visión más amplia y filosófica del universo, que busca encontrar un.
El cosmos y el universo

El Universo es todo, sin excepciones. Materia, energía, espacio y tiempo, todo lo que existe forma parte del Universo. También se le llama Cosmos. Las ciencias que lo estudian son varias, en especial dos: la astronomía y la cosmología. El Universo es muy grande, pero quizás no infinito.
Calaméo EL cosmos y el Universo

Sin embargo, para responder "qué es el Universo", desde una visión científica, la Agencia Espacial Europea ( ESA, por sus siglas en inglés) apunta lo siguiente: " El Universo es todo lo que podemos tocar, sentir, percibir, medir o detectar. Abarca las cosas vivas, los planetas, las estrellas, las galaxias, las nubes de polvo, la luz e.
El cosmo y el universo

El telescopio espacial James Webb abrirá una nueva ventana al cosmos, desde donde veremos estrellas, galaxias, planetas y otros objetos como nunca antes. En el primer episodio en español del podcast Universo Curioso de la NASA, conversamos con dos miembros hispanos de esta misión histórica, que llevará al espacio al telescopio espacial más grande, complejo […]
Diferencia entre cosmos y universo Que Diferencia

Universo. El Universo es el espacio y el tiempo que abarca todo aquello que existe, es decir, todos los tipos de materias, los planetas, la energía, la luz, las estrellas, los satélites, las galaxias y otros objetos celestes, incluso, las leyes y las constantes físicas que los gobiernan. Por ello, el Universo es difícil de explicar o medir.
El cosmos y el universo

El cosmos abarca mucho más que el universo visible, ya que incluye todas las galaxias, estrellas, planetas, asteroides, cometas, partículas subatómicas y todo lo demás que existe en el espacio. El universo visible es mucho más pequeño que el cosmos en su totalidad, ya que se limita a un radio de aproximadamente 14 mil millones de años.
El cosmos y el universo

Orígenes de la teoría. Un sacerdote belga, de nombre George Lemaître, que vivía en Lovaina sugirió por primera vez la teoría del big bang en los años 20, cuando propuso que el universo comenzó a partir de un único átomo primigenio. Esta idea ganó empuje más tarde gracias a las observaciones de Edwin Hubble de las galaxias.
QUÉ ES EL COSMOS

Cosmos, en su sentido más general, es sinónimo de universo o mundo, el conjunto de todo lo existente, aunque también es empleado para referirse exclusivamente al espacio exterior a la Tierra. 1 2 El término cosmos además denota orden y organización, es el universo visto como un sistema ordenado o armonioso. 3 4 .
El cosmo y el universo

NASA. Jul 12, 2022. RELEASE 22-071. Este paisaje de "montañas" y "valles" salpicados de estrellas brillantes es en realidad el borde de una joven región cercana de formación estelar llamada NGC 3324 en la Nebulosa de Carina. Capturada en luz infrarroja por el nuevo telescopio espacial James Webb de la NASA, esta imagen revela por.
El Cosmos y El Universo by diego antrus issuu

El universo es el conjunto de todas las entidades físicamente detectables que interactúan entre ellas dentro del espacio-tiempo de acuerdo a las leyes físicas definidas. Sin embargo, el término también se utiliza informalmente en sentidos contextuales ligeramente diferentes y alude a conceptos como cosmos, mundo, naturaleza o realidad. [1] Su estudio, en las mayores escalas, es el objeto.
El cosmos y_el_universo_pptx_11

Pero esa es la historia que nos cuentan los científicos, la de la "edad oscura" que reinaba en el universo antes de que las primeras estrellas se encendieran. Y muy pronto tienen la intención de.
¿El Cosmos Y El Universo? Open AI Lab

Diferencias entre cosmos y universo. El universo es todo lo que existe, mientras que el cosmos se refiere a la estructura y organización del universo. El universo incluye la materia, la energía, el tiempo y el espacio, mientras que el cosmos se refiere a la disposición de las galaxias, estrellas y planetas. El universo es un concepto más.
El cosmos y el universo

Y aquí radica el problema: el valor extrapolado es aproximadamente un 10% más pequeño que la constante de Hubble que se observa hoy. Fuente de la imagen, Getty Pie de foto, El universo está en.
El cosmos y el universo Cursos Online Web

Se estima que el universo tiene unos 13 800 millones de años.Mientras que el sistema solar tiene 4600 millones de años, la vida en la Tierra ha existido durante, aproximadamente, 3800 millones de años, y los humanos han existido solo unos pocos cientos de miles de años. "En otras palabras, el universo ha existido aproximadamente 56 000 veces más que nuestra especie", reflexiona la NASA.
El Cosmos y El Universo PDF

La discusión anterior probablemente te ha impresionado que el universo es extraordinariamente grande y extraordinariamente vacío. En promedio, está 10 mil veces más vacío que nuestro Galaxy.. Pero, hay otra manera de ver lo que has aprendido de nuestros primeros vislumbres del cosmos. 1.E: La ciencia y el universo - Un breve recorrido.
.